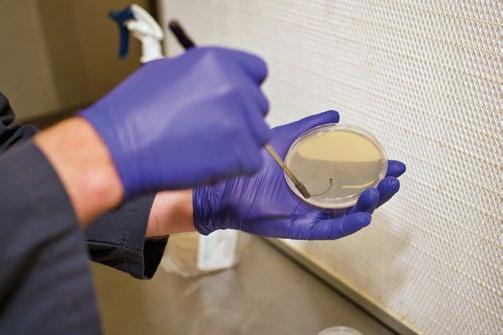

NORTHEAST






Pairs with any drink
Precise microdosing
Fast-acting effects

WES ABNEY CEO & FOUNDER wes@leafmagazines.com
MIKE RICKER OPERATING PARTNER ricker@leafmagazines.com
TOM BOWERS CHIEF OPERATING OFFICER tom@leafmagazines.com
DANIEL BERMAN CREATIVE DIRECTOR daniel@leafmagazines.com
TERPODACTYL MEDIA CONTENT DIRECTOR amanda@leafmagazines.com
MIKE GIANAKOS ONLINE EDITOR mikeg@leafmagazines.com
KAYL WOHL COPY EDITOR kayl@leafmagazines.com
MICHAEL CZERHONIAK ADVERTISING SALES michael@leafmagazines.com
PAIGE RICHARDS ADVERTISING SALES paige@leafmagazines.com
For our fifth consecutive year, we’re pushing the boundaries of societal norms by venturing into the kaleidoscope through plant medicine. This time, Denver, Colorado artist Randal Roberts blesses us with a different bend on "The Simpsons" animated show with a work that has become one of the most popular blotter art pieces of all time. “My work is the intersection of art and spirituality,” says the famed psychedelia artist. “And through blotter art, I’ve joined the ranks of the renegades.”
ILLUSTRATION BY RANDAL ROBERTS @RANDALROBERTSART
CONTRIBUTORS
WES ABNEY, NATIONAL NEWS
ADHDDEAD, FEATURES + PHOTOS
DANIEL BERMAN, PHOTOS
BOBBY BLACK, FEATURES + DESIGNS
JOSHUA BOULET, ILLUSTRATION
TOM BOWERS, FEATURES
RYAN HERRON, FEATURES
REX HILSINGER, FEATURE + PHOTOS
MATT JACKSON, FEATURES
JESSE JOHNSON, FEATURES
JAKE KERN, FEATURES
ROGER KISBY, PHOTOS
LEXI PADUSSIS, SALES
MIKE RICKER, FEATURES
RANDAL ROBERTS, ILLUSTRATION
BRIAN SANNER, FEATURES + PHOTOS
TERPODACTYL MEDIA, FEATURES + PHOTOS
JAMIE VICTOR, DESIGN
BRUCE & LAURIE WOLF, RECIPES

While I might tell stories of trips past or pontificate on how psychedelics will be legalized, I am instead using this space to urge for peace during a time of immense need for our community and country.
Last month, the world witnessed an attempted assassination of former President Trump. These are unprecedented times, with nuclear powers on the brink of major conflict, and it has never been easier to hate, to block and to “other” people or groups with different views. Social media has amplified this division, along with the dangerous rhetoric of division spewed by media and politicians on both sides desperately clinging to power.
As the road to destruction continues, I must share a sobering warning: Without change, love, and acceptance of others, we will remember this moment as a harbinger of what is to come, rather than the penultimate chance for truth and change before this chapter in history is fully written.
In these times, I reflect on the words of Dr. Martin Luther King Jr., who, despite the hatred, racism and evil so present at the peak of the civil rights movement, chose to see the battle for America’s future through a clear and powerful lens. “Returning hate for hate multiplies hate, adding deeper darkness to a night already devoid of stars. Darkness cannot drive out darkness; only light can do that. Hate cannot drive out hate; only love can do that.”
I am here to proclaim that it’s hard to hate with a joint in hand or with THC feeding our endocannabinoid systems. It’s even harder to see another human as other, less than, or evil for simply praying, loving, or voting in a way you disagree with — that is, once you have experienced an ego death during a trip.
“THERE IS NO ROOM FOR HATE IN A HEART AND MIND THAT’S OPENED BY PSYCHEDELICS AND KEPT ON THE POSITIVE VIBRATION OF CANNABIS.”
There is no room for hate in a heart and mind that’s opened by psychedelics and kept on the positive vibration of Cannabis. This is the healing of the nations, the light against darkness, that reemerges at a time of incredible need for our people and our planet.
We are creators of targeted, independent Cannabis journalism. Please email us to discuss advertising in the next issue of Northeast Leaf Magazine. We do not sell stories or coverage. We can offer design services and guidance on promoting your company’s medicinal, recreational, commercial or industrial Cannabis business, product or event within our magazine and on our website, LeafMagazines.com. Email paige@leafmagazines.com to start advertising with Northeast Leaf!


America is the greatest country in the world, the country that fought a civil war for freedom and equality for all, and today secures world peace and prosperity through our own example of this vision of democracy. What greater opportunity could exist then, to share entheogenic and psychedelic plants and medicines, and heal our people for the benefit of the world?
“When our days become dreary with low-hovering clouds of despair, and when our nights become darker than a thousand midnights, let us remember that there is a creative force in this universe, working to pull down the gigantic mountains of evil, a power that is able to make a way out of no way and transform dark yesterdays into bright tomorrows.”
Whether you believe in God as our creator, and these plants and medicines as His gift to humanity as I do, or seek to find your own creator and inner peace, psychedelics offer a pathway that should not simply be walked. We must proselytize our truth for the world to see!
That’s how healing truth will spread, like a spore in the wind, as a little light shining all the brighter for the surrounding darkness.



With Joe Biden out of the campaign for president and Kamala Harris the presumptive Democratic candidate for 2024 at the time of printing, her past prosecutions of Cannabis users are receiving fresh scrutiny in news and social media.
USA Today reported that within hours of Biden’s dropout statement on X, internet searches surged on Harris, including her positions on Cannabis legalization. As the District Attorney of San Francisco, she oversaw over 1,900 convictions for Cannabis crimes and later laughed in a recorded interview when asked about whether she had smoked Cannabis during that period.
"...voters and lawmakers alike are wondering how her shift on Cannabis might play out if she wins the presidency."
Former Hawaii Rep. Tulsi Gabbard referenced this in the 2020 presidential debates, and her questioning of Harris’ record preceded Gabbard’s departure from the race.
Harris has also been dragged by mainstream media for keeping nonviolent California prisoners incarcerated beyond their scheduled release dates, which contradicts a 2011 Supreme Court ruling requiring the state to reduce its prison population. A 2014 memo from her office as attorney general “claimed that nonviolent offenders needed to stay incarcerated, lest they lose bodies for fire camps [prison labor] in the wildfire-plagued state.”
She also famously fought to keep an innocent prisoner on death row with the California Innocence Project, sharing her statement that “even if Danny [Larsen] was innocent, his conviction should not be reversed because he waited too long to file his petition.”
While hardly a progressive prosecutor, voters and lawmakers alike are wondering how her shift on Cannabis might play out if she wins the presidency.

The Biden-Harris administration has taken the largely symbolic gesture of pardoning federal Cannabis convictions, issuing 211 pardons to date. The administration has also overseen the proposal for rescheduling Cannabis to Schedule 3, a move that many in the Cannabis industry are uncertain of.
She has gone on the record, saying, “Marijuana is considered as dangerous as heroin and more dangerous than fentanyl, which is absurd, not to mention patently unfair,” as reported by USA Today.
The question of whether she’ll live up to a tweet, stating, “Nobody should have to go to jail for smoking weed,” will be largely up to the voters first this fall.
10
The number of certificates of operation out of 200+ applications, granted in the first batch of licenses issued to cultivators and processors in Ohio, which has yet to license any recreational marijuana retailer businesses and has so far declined to set a date when 21+ sales may begin.
25%
The estimated percentage of Cannabis sales in Illinois that come from out-of-state visitors, according to Illinois Gov. J.B. Pritzker (D), in a speech addressing the International Cannabis Bar Association in July.
$ 1.2b
The projected value of the Cannabis market in Thailand by 2025, according to Reuters, which notes that the country must still finalize its 2022 laws regulating and decriminalizing Cannabis for recreational use.
27% 64%
The percentage of Cannabis businesses that say they are operating profitably, according to a survey by Whitney Economics in a report for the Minority Cannabis Business Association.
The percentage of support in Florida in favor of a state marijuana legalization ballot initiative in the upcoming election.
47,000
The number of non-citizens that federal officials deported for violating marijuana possession laws between 2002 and 2021, according to a report from the Drug Policy Alliance and Human Rights Watch, reports NORML.org.
overnor Ron DeSantis, famous for touting deregulation and freedom in Florida, is scared that “the state will start to smell like marijuana” if the drug is legalized in the upcoming election.
Long accused of blowing hot air, it’s apparent that DeSantis is not interested in switching to bong hits, based on his recent statements at a Florida Sheriffs Association conference where he doubled down on anti-pot rhetoric. He went on a righteous rant full of stoner disinformation, asserting that Cannabis legalization “is not going to be good for quality of life,” and that “most people [in Colorado] regret that [legalization] happened.” Polling shows that two-thirds of the Rocky Mountain High region participants believe legalization was good for the state.

"He went on a righteous rant full of stoner disinformation, asserting that Cannabis legalization “is not going to be good for quality of life,”
The misinformation about pot wasn’t limited to the governor, as Smart & Safe Florida responded with some mistruths of their own. They’re behind the measure to legalize, stating that Cannabis is already in Florida, “but in a dangerous form often laced with unwanted, harmful chemicals.” This isn’t necessarily true, but statistics and history do support the assertion that legalizing weed leads to safer products and fewer arrests.
While DeSantis might be scared of “a limitless constitutional right to possess and smoke” weed, he might want to take a reality hit and realize that’s what all Americans, and many Republicans, feel should be their right.

The cookie was crumbling in New Mexico earlier this summer as a Cookies store grand opening party was met with huge fines and an extra dose of judgment.
Regulators fined the company that owns the Cookies store $350,000 for five violations during the grand opening, including charges of allowing a minor on site and promoting the consumption of Cannabis.

"...violations included promoting overconsumption, allowing public consumption of alcohol and having Cannabis products on display outside the license area."
While it’s still legal to take a kid into the liquor store if the parent is buying booze and tobacco, it’s a major no-no with weed. Other violations included promoting overconsumption, allowing public consumption of alcohol and having Cannabis products on display outside the license area.
With a huge turnout to see Berner and purchase Cannabis legally at the store, this expensive, violation-filled party sounds both fun and possibly worth the legal expense due to the free press exposure.
The seriousness of promoting smoking weed was emphasized by Andrea Brown, a spokeswoman for the New Mexico Regulation and Licensing Department, in a statement to Yahoo News: “We are hopeful that this licensee recognizes the gravity of the violations and will prevent this type of noncompliant activity from occurring ever again.”



Established in April 2017, Highbrowhas rapidly become one of Maine's leading Cannabis brands, with six dispensary locations. Half of these dispensaries serve medical patients, while the other half caters to recreational use. Renowned for their infused beverage line, Highbrow also offers an extensive range of in-house flower, edibles, concentrates and CBD products.

SUMMER EVOKES thoughts of warm and sunny days, quality time with friends and ice-cold drinks that offer a refreshing break from the heat. A personal favorite of mine is a delightful glass of fruit punch accompanied by some fresh fruit, a nostalgic treat that brings back to the summers of my youth. Fortunately, Highbrow offers a hash rosin-infused fruit punch in their original 100mg THC formulation. For those those who prefer a stronger dose, they've also introduced a 200mg version of this beverage.
“CLOSING MY EYES, I FOUND MYSELF MENTALLY WHISKED AWAY TO A TROPICAL ISLAND.”
With glee, I opened my bottle and poured its contents into a glass filled with ice. The aroma of guava and berries permeated the air as the fruit punch ran over the ice cubes. After the pour, I swirled the glass softly, allowing the ice to impart a crisp chill. Content with the cooling effect, I lifted the glass to my lips, took a generous gulp, savoring the taste of guava, berries and other fruits on my taste buds before swallowing. Closing my eyes, I found myself mentally whisked away to a tropical island. Soon after, a profound sense of happiness and relaxation washed over me, easing away all the day's discomforts.
If you are planning a summer party or you just want to relax after a long day and have a high tolerance like me, I highly suggest keeping a few of the Highbrow’s 200mg hash rosin-infused fruit punches in your fridge. There is also a blueberry lemonade option, and I certainly will be including them in my summertime festivities!

highbrowmaine.com @highbrowofmaine 100mg or 200mg THC per beverage



POW! ZAP! BANG! This hash hits so hard that it must be superhuman. Michelin Terps’ Superboof is a single-source cold-cure hash rosin that feels like being a superhero in your own mind. Smoking this special cross between Black Cherry Punch and Tropicana Cookies can turn a normal, average day into an adventure of epic proportions.



“THIS SPECIAL HASH HAS THE POTENTIAL TO MAKE EVEN THE MOST MUNDANE MOMENTS FEEL MAGICAL.”
THIS AWARD-WINNING concentrate from Massachusetts checks all the boxes with great flavor, effects, looks and potency. It’s no surprise this powerful little jar knocked out the competition and took home 1st place at Mila the Hash Queen’s inaugural Dab-A-Doo Northeast. As a judge for the competition, I can confirm that this hash stands out among a deep lineup of high-grade offerings. Like a valuable treasure, a perfect pearlescent, slightly off-white orb of terps is waiting for you upon cracking the jar. The hash reeks of candied citrus terps that burst out and attack your senses. It’s so loud it feels like a punch in the face by the intense cherry and bright orange notes. Impressively, the nose translates superbly to the palate, providing a delicious dab that both tastes and feels amazing. The effects of Superboof might give you the sense of unlocking a hidden, secret superpower. It could make you feel like The Flash, with a buzzy, energetic, mood-boosting high that may also offer mental clarity and spark creativity and focus. Whether powering through your to-do list or jamming out to your favorite music, this special hash has the potential to make even the most mundane moments feel magical. If your biggest adversaries are a bad mood, low energy and missing appetite, then you better hit your “hash signal” and call on the extraordinary talents of your newest hash hero, Superboof from Michelin Terps. This hash just might be the hero we need to save us from the attack of the mids. Act fast if you get a chance to try these terps; if you miss out, it might end up being your villain origin story.

@michelin_terps
Lineage: Superboof (Black Cherry Punch x Tropicanna Cookies)



















Whole bud flower is infused with a proprietary process that combined diamonds, natural botanical terpenes and pure kief all contained within the pre-roll to produce a potent flavor explosion and high THC content for that desired Lift o or couch lock without the mess and burn of a traditional pre-roll.







































































HERE’S HOPING THAT AUGUST allows you to get some vacay, or at least summer Fridays offering you time to chill. You deserve it! These recipes are my go-to for summer entertaining — simple and very delicious. I have infused the recipes with my favorite summer strain, Apples and Bananas from Pruf Cultivar. This hybrid is relaxing but not tiring, quite stoney but not debilitating. Last week, I overindulged in the very potent and delicious strain, Prada Colada, also from Pruf, reminding me that there is nothing wrong with a little restraint. It blows my mind that I still overdo it. I should have learned by now that “less is more” — my company’s mantra! Laurie@Laurieandmaryjane.com


1. In the bowl of a food processor, puree the mustard, lemon juice, Worcestershire and garlic. With the machine running, drizzle in the oils. Transfer the dressing to a jar and add the Parmesan, salt and pepper.
2. Place the romaine in a serving bowl and toss with the dressing to coat. Top the salad with the chicken and croutons and serve.
3 tablespoons Dijon mustard
2 tablespoons lemon juice
1 teaspoon Worcestershire sauce
2 cloves garlic, smashed
6 tablespoons olive oil
4 teaspoons canna-oil
1/3 cup grated Parmesan Salt and pepper
2 romaine lettuce hearts, chopped
1 1/2 cups chopped or shredded cooked chicken
2 cups croutons
Shredded Parmesan for garnish

1 pound skirt, flank or hanger steak
Salt and pepper
2 pounds small potatoes
1/4 cup sherry vinegar
4 teaspoons canna-oil
1 tablespoon olive oil
1 teaspoon ground cumin
1 tablespoon olive oil
2 scallions, cut in pieces
5 ounces green beans, trimmed, cut into pieces and steamed
4 cups chopped romaine lettuce
1/2 cup chopped red onion
4 radishes, thinly sliced
1. Preheat grill to medium-high heat. Season the steak with salt and pepper and grill until desired degree of doneness.

2. In a medium pot, quarter and cook the potatoes until tender, about 20 minutes. Drain.
3. In a medium bowl, whisk together the vinegar and oils. Add the cumin and salt and pepper to taste.
4. In a medium skillet, heat the olive oil and add the scallions, potatoes and green beans and cook for 4-5 minutes.
5. In a large bowl combine the lettuce, steak, red onion, radishes and cooked vegetables. Toss with the dressing and serve.



4 strips bacon
1 large shallot, minced
2 cloves garlic, minced
2 tablespoons brown sugar
6 tablespoons balsamic vinegar
3 tablespoons orange juice
1 tablespoon Dijon mustard
2/3 cup olive oil
4 teaspoons canna-oil
8 handfuls mixed salad greens
20 large cooked shrimp, cut into pieces if desired
1 red onion, thinly sliced 20 grape tomatoes
1 avocado, pitted peeled and cut into chunks. Toss with lemon juice Salt and pepper
1. In a medium skillet over medium heat, cook the bacon until crisp. Transfer to paper towel to drain, reserving the drippings in the skillet. Chop the bacon.
2. Heat the bacon drippings, add the shallot and garlic and saute for 2-3 minutes. Add the brown sugar and cook an additional 2 minutes.
3. Scrape the contents into a blender. Add the vinegar, orange juice, mustard and the oils. Blend well.
4. In a large bowl, toss the greens with the shrimp, red onion, tomatoes and avocado. Add the dressing and toss again. Season with salt and pepper.
































For those who choose to stand out, be di erent, and create their own path




YOU DESERVE a little treat, and Sugar Babiez from Good Life Gardens will delight you with a complex, candyforward terp profile and more power than you might expect from a Runtz cross.
A rare, treasured strain from Dungeons Vault Genetics that was given to only a few trusted growers, Sugar Babiez is Runtz x Sugar Daddy. Testing at over 30% THC, Sugar Daddy’s lineage of Wedding Cake x Grandpa’s Breath (OG Kush x Grand Daddy Purp) provides a deceptive, underlying potency beneath all of the sweetness. Be careful around this one; it’s so sweet you might not realize what a heavy hitter she is.
On the inhale, Sugar Babiez delivers a burst of true candy that melts into a complex blend of hops, lavender, cinnamon, orange and apple all wrapped up in a subtle, earthy finish. It’s a tantalizing flavor profile that is seemingly familiar before shifting into a complex, but not muddied, medley of dessert flavors topped off with a hint of kush.
The high from Sugar Babiez is equally enchanting; a cerebral buzz may lift the spirits and spark creativity, similar to a sugar rush from a bag of candy. However, you might experience a sugar crash as things settle in, with a pleasurable, narcotic full-body high that calms the mind and relaxes the body, leaving you smacking your lips from the tasty terps. The sensation may sneakily spread through your system, effortlessly soothing away any excess stress and tension.
This tasty knockout has not gone unnoticed in the Cannabis community. Good Life Gardens’ version of the strain is an award winner, including 1st Place Hybrid Flower and Best Overall Flower at the 2023 Boston NECANN Cup and 2nd Place Hybrid Flower at the 2024 Boston NECANN Cup. These accolades reflect not only great genetics but also the care and attention to detail their team puts into every plant. If you can get your hands on it, this plant is definitely one worth spoiling yourself with.

@good_life_gardens | 30% THC


EVERY TRIP IS UNIQUE, and the same dosage or drug might have completely different effects on two similar people, so use caution when taking a first step into the world of psychedelics, especially when outside of clinical settings. Lingo is important, so we’ve added a few key terms and definitions for safe exploration.
Under the influence of psychedelics
A dose of psychedelics
Mushrooms
Psilocybin, or magic mushrooms, of which there are many varieties and effects
LSD
Properly known as Lysergic acid Diethylamide, LSD was discovered by Albert Hoffman on 4/19/1938 and produces long, intense trips and shows benefits for depression, mental health traumas, and end-of-life therapy.
Dimethyltryptamine is found in countless plants and is hypothesized to be produced in our brains during sleep, birth and death. DMT is used in Ayahuasca ceremonies or synthesized separately for consumption. This powerful drug can induce out-of-body journeys. For more information, check out the book “The Spirit Molecule” or read trip reports at erowid.org.
Legal in most states, Ketamine provides therapy in a clinical setting for depression, anxiety and other mental health issues, and has been shown to help with alcohol dependency.
Ibogaine
Illegal in the US, this plant-based medicine has been shown to clear neurochemical receptors, providing a one-time treatment that can end physical addiction to opiates or benzos.
MDMA
Also known as Molly, this wonder drug helps with PTSD and depression. Check out MAPS.org for more info on how this misunderstood drug can help with many issues and be a safe party drug when consumed carefully.


Whether you are a newb looking for a first melt or an old head seeking to relive some glory days with a fresh trip to the ego death factory, look no further than our comprehensive guide to getting started on a trip.
Psychedelics change our entire perception of reality, ego, memory, feelings and even how our brains program and process information. Neuro-linguistic programming can help rewire the brain from traumas and addiction, with or without psychedelics. That said, whenever your world is shattered, there will be those who skip around in bliss and those who start to process the past and present through a new lens. This is having a bad trip, which often involves reprocessing, and it can be triggered even when the intent of an experience is not therapeutic. Those in the grip of a bad trip need a safe space, low light, gentle music and time. They might loop in behavior and repeat phrases or revelations, or drift in and out of lucidity as the drugs process. With the DMT derivative Ayahuasca experience, purging via puking and pooping is common along with the purging of dark energy, thoughts and traumatic experiences, and is to be expected as part of the trip.
Having a qualified trip sitter is just as important as booking a good babysitter when you head out of town. Much like childcare, it’s important to have a sober and aware person sitting with an individual or group when taking large amounts of psychedelics. This person can keep everyone safe during the trip and prevent those under the influence from leaving the safe space.
The only place worse than behind the wheel is in jail while tripping, so don’t risk it. We would also share this recommendation for commercial air travel, but not necessarily for the bus, where you can jump off if the accordion stretch section starts talking to you in a French accent.
These powerful drugs should not be viewed as a guaranteed good time in the way an edible or dab can consistently be relied upon. Always be prepared for a trip to need time for introspection, weirdness and for perception to change — if a storm of bad feelings hits, know that it will soon pass.
This common phrase refers to when and where you choose to experience psychedelics. It’s always advisable to pick a safe, comfortable setting that is free of stress, annoyances or distractions that you might not be able to deal with. For some, this is a favorite couch with lots of blankets or out in the woods with room to roam and howl at the moon. Always avoid situations where you are unable to stay for multiple hours and have your hydration and comfort items ready. Something as simple as picking a stuffed animal or operating a sink might become supremely difficult when under the influence, so make those decisions before starting your trip.
Macrodosing or taking a hero dose will not give you superpowers in the Marvel sense, but will send you on a deep journey of personal introspection. Generally viewed as taking anything over one gram of mushrooms or two hits of a different psychedelic like LSD, going macro means a big dose. This can also be called a therapeutic dose, which can go up to 3.5 grams or more, depending on the type of mushroom and potency. While it sounds intimidating, taking a large dose of psychedelics is where the real trips happen, both in the fun sense and in a therapeutic setting. True ego death and the reshaping of neurological pathways come from large doses, opening the mind, spirit and body to change and potential healing. Large doses can also lead to intense processing and bad trips, and should only be taken with a safe space and a trip sitter present.
Microdosing has been en vogue and going viral for the last few years, as everyone from celebs to moms try a new buzz for creativity, focus, depression and a fresh outlook. Microdosing refers to taking a small dose of Psilocybin (mushrooms) in the amount of 0.1 to 0.3 grams of a fruiting body (mushroom cap).
Clinical data suggests that mushrooms or other psychedelics like MDMA and LSD taken at small doses consistently reduce symptoms of stress, depression, anxiety and negative mental health symptoms including PTSD.
Anecdotally, users often report an influx of energy, focus and motivation, as well as a sense of things being sparkly and wonderful when under the influence of a microdose.
The success of clinical studies seems to suggest that microdosing on a regular schedule, combined with counseling or therapy, could significantly help alleviate negative mental health symptoms and offer an alternative to pharmaceutical treatments.
It’s important to remember that psychedelics change your neurochemistry and brain-bodymind connection. This is not to be viewed lightly, as one is both more open to programming and positive experiences, becoming suggestible and altered during the process. It’s important to be conscious of the music and media you consume while under the influence, understanding that your brain is open in a way that daily consciousness does not offer.
We do not recommend microdosing for work or school, although many anecdotal reports indicate that this works for some individuals. Above all, we advise treating any use of psychedelics with a therapeutic intent to be consumed in a setting safe for healing and growth, which most workplaces are not conducive to.
A note on dosing your microdose: the intent is not to feel high, but to have a small, almost imperceptible effect on your daily baseline that adds value to a normal daily experience without inducing a full trip. Start with 0.1 grams of mushrooms and give it time.
For this writer, a 0.3-gram dose is a few hours of Pink Floyd and a lost day of productivity, so trusting a dose before work or a deadline is never advisable.
Many states like Oregon now offer Psilocybin therapy, as well as opportunities for therapy paired with Ketamine, MDMA and more. You can find these therapy centers online, though some therapies like Ibogaine are generally outside of the US. Note that insurance will not cover most therapy opportunities.
In the world of psychedelics, 1+1 does not necessarily equal 2. The effects of 0.2 and 0.4 grams are not double; amounts stack up exponentially to where the difference between a half gram and a gram of mushrooms is a trip with 10 times the strength. Therefore, taking a 0.1 mircodose and feeling great does not mean that taking another will intensify that greatness. It could instead change an energetic micro to a thoughtful melt. A good rule of thumb is to commit to a dose and ride it out. Rarely does eating more end up as fun as planned, and if it’s really needed, you can always eat more.
While it sounds intimidating, taking a large dose of psychedelics is where the real trips happen, both in the fun sense and in a therapeutic setting.
Amongst professional psychedelic administrators, there is a dislike for the word shaman, as it has been at times overused or co-opted by those seeking money or power versus spreading healing. The cultural appropriation of the term often involves individuals making IG videos selling services — a true shaman would never, nor will they operate out of a van down by the river. This doesn’t imply that all who identify as shamans are charlatans, but that you’ll likely find them organically running retreats versus in the urban jungles of LA.

If it’s on the internet, it’s probably not what it claims to be, as selling psychedelics is illegal in many places, especially online. Be careful and always try to find psychedelics from a local, trusted source not focused on making money, but sharing healing medicine.
Just as we would not advise seeking love via overseas websites, the same pitfalls awaiting a hopeful heart can also befall a trip-seeking psychonaut. Always be careful when booking a trip, especially to the jungles of South America. Many scams and services over-promise and under-deliver, so thorough research beforehand and seeking references are essential. Other places like Amsterdam offer consistent mushroom and Cannabis experiences and are generally safe to travel to, but you’ll still want a real trip plan before you indulge in a chocolate truffle and wander the canals.

EComedian
Comedian
xploring the depths of one’s own mind can be a beautiful and dynamic journey. It can often be hilarious. And sometimes dangerous. Shane Mauss is no stranger to the power of psychedelic compounds and their potential to impact how we perceive the realms within and without ourselves.
HIS RESULTING BODY OF WORK illuminates, educates and entertains. Here is a man who has consumed the majority of psychedelic substances known to humanity and lived to tell the tale.
He has released a documentary, “Psychonautics: A Comic’s Exploration of Psychedelics,” recorded a decade’s worth of shows for his podcast, “Here We Are,” and riffed on tripping in comedy specials and various late-night talk show appearances.
One could say that Mauss pushed the boundaries so we don’t have to. And he’s definitely found his limits.
There was a time when Mauss didn’t hesitate to eat mushrooms and didn’t fear the power of psychedelics.
Then, a few years ago, a heavier-than-intended Ayahuasca journey unearthed the comic’s latent, undiagnosed bipolar disorder.
“I thought that psychedelics were just always amazing,” Mauss said. “Even when they were a little difficult, that was just part of it. Then I lost my mind. I’ve been much more skittish ever since.”
uses humor to report from the realms of the mind
humor to report from the realms of the mind
As a psychonaut who built his career and public persona around psyche-spelunking, it’s been a difficult journey to balance his diagnosis with his exploration of the mind. It adds a complicated layer to the onion.
“I have two things that I hate now,” he said, “one of which is that mushrooms are my favorite psychedelic, and I’m now more scared of them than I’ve ever been. I have rules about when I do them. And two, when things feel really good in my life now, because I’ve had some severe manic episodes, I can’t just appreciate feeling good anymore. I am on alert a little bit. I definitely don’t do psychedelics if things are going really well, for fear that it’ll lead to a manic episode.”
That doesn’t mean he doesn’t trip. But he’s careful and intentional with his choices.
“I go on streaks,” he said. “I got very into ketamine for a while because that never made me feel unsafe in terms of having a manic episode … DMT is something that I’m kind of looking to get back into. I’ve had so many DMT experiences, and just oddly enough, it just only gets weirder and weirder and weirder. I definitely hit a wall with DMT where things were just getting so insane and weird and confusing that I needed a little break for a while.” >> Continues next page
“I had a fairly closedminded-ish upbringing and had my own biases and prejudice and everything else that as a kid I bought into, so psychedelics were very opening and mind-expanding in that way for me.”


Just like with anything, a psychonaut’s relationship with psychedelics evolves over time. In Mauss’ case, that evolution experienced an acceleration event with his diagnosis. Now, he’s more interested in the growth potential that swells immediately after a trip than he is in the trip itself.
“When I was young, it was to see a cool visual or to be in this altered state and just to feel different,” Mauss said. “That’s what I was after. With enough experience, all of the visuals and those sorts of things kind of got old and didn’t really do as much for me. (Now) it seems to be that the trip is just a thing that I get through so I can have the integration afterward, which is what I seem to enjoy the most. It’s funny: because I’m on a psychedelic tour, I’m doing the least amount of psychedelics in my life because the tour is so busy that I almost never have two or three days to set aside to integrate an experience. I don’t like doing a psychedelic experience if I don’t have at least a full day free afterwards.”
The evolution of his relationship to psychedelics seems to be happening in tandem with a sea
change in the public perception and use of entheogenic, mind-altering medicines. Mauss points out that the original archetypical American psychedelic explorer of the free love generation saw the experience through an idealistic, kaleidoscopic lens. Not only has the popularization and mainstream implementation of these powerful substances changed how they’re used and why, but it’s also changed the profile of people who use them.
“The idea that everyone would do acid and turn to universal love and peace was probably a little naive, but I think that I would have believed that more (during the Woodstock era),” Mauss said.
“I had a fairly closed-mindedish upbringing and had my own biases and prejudice and everything else that as a kid I bought
into, so psychedelics were very opening and mind-expanding in that way for me. That was always my assumption too, that it would make people more empathetic and sympathetic and mindful and caring. But people didn’t microdose before either, so people were having experiential changes. Now people are doing these optimizing doses, so it’s in this supplement grift kind of category of optimizers. I think if you would go back to Woodstock and go like, ’Hey, in the future, people are going to do small amounts of LSD to get better at punching people in the head for sport in gladiator arenas.’ I think that would’ve surprised people.”
Mauss is currently in the middle of a marathon tour that kicked off at Area 15, the Las Vegas home of
The Leaf asked Shane Mauss for advice on what budding psychonauts should avoid in their early experiences. Here’s what he had to say:
“I THINK the mirror is not for first-timers. I think you should have your sea legs a little bit because there are certain things that can really add to a psychedelic experience but can also be much harder to navigate. I would never be like, ’Hey, you know what? You should do psychedelics and get in a hot tub.’ That’s about my favorite thing in the world, but I also know the right time. It’s after I’ve peaked and I’m coming down. There’s something about it that can bring on another wave for me, and I feel comfortable. Psychedelics can already be an overwhelming experience, so anything that can make it more overwhelming is something you want to have more experience with before you try.”
“I think bathrooms generally are easy to get yourself lost in. There’s just too much stuff going on with bathrooms: germs, nudity, hygiene, tiles. It’s weird, especially when you’re in public and there’s just too much going on. I would always recommend a first-timer just have a plan: get in and out as soon as you can. It’s not some hard-andfast rule or anything, but it is like
Meow Wolf’s amazing psychedelic tourism attraction Omega Mart. The shows are a vibrant blend of storytelling set against a visual backdrop from his collaborator Michael Strauss, a VJ who creates digital eye candy-scapes to complement the material.
“I try to combine my experiences with ideas that I have about perception,” he said, “to get at why a human brain would be having this experience at all, so that it’s less about me and more about a universal experience.”
He’s found that the acceptance of psychedelics into the mainstream brings a wider array of people to his shows.
“Being 44, I went through the D.A.R.E. program and all of that stuff as a kid. I mean, I never thought in my wildest dreams that psychedelics would be as
a quick, dirty heuristic, more than some dogmatic rule that’s going to be the right thing for everyone. But I find that there are things like seeing yourself as others see you [by looking in the mirror on psychedelics], I think is something that most people will benefit from even early on, even if that’s a little harder.”
“But then there’s things like looking deep into your dilated pupils and looking into the infinite space of your pupils … that’s almost concerning the first time that it happens to you. But I do all sorts of stuff. I mean, I’ve driven while tripping. I do all sorts of things that I don’t ever recommend to people. My best LSD experience of my life was when I accidentally did a bunch LSD, and
then I had to drive for 12 hours. It was one of the greatest days of my life. I’m not recommending that to anyone, clearly. I’m not recommending it to myself. I’m not going to replicate the experience. But it was amazing. It would be dishonest of me to say that it wasn’t one of the single greatest days of my entire life. It was beautiful.”
“I would always recommend a first-timer just have a plan: get in and out as soon as you can. It’s not some hard-andfast rule or anything, but it is like a quick, dirty heuristic, more than some dogmatic rule that’s going to be the right thing for everyone.”
-On using the bathroom while tripping.
“TV is another one. I would generally stay away from it. It is funny because I think early on you’d hear people be like, ’Oh, what we should do is eat mushrooms and watch a trippy movie.’ I think that if you have animal documentaries on mute with just regular music playing in the background, that’s a nice atmosphere — something that’s just ambient that you don’t have to be watching, but you can also get sucked into if you want to. But it also leaves a lot to the imagination and interpretation and everything of the experience. Often, whatever random song happens to be playing will influence your perception of
how these animals are behaving. Jimmy Buffett’s on, and you’re like, ’Wouldn’t it be great to be an animal like that?’ And then Pink Floyd starts in on the dark stuff, and you’re like, ’Oh my God, I hope they make it!’ I once watched ’Requiem for a Dream’ on mushrooms. I’d heard it was a trippy movie.” (Spoiler: It was a horrible experience.)
“I actually have a pinned post on my Instagram trying to dissuade people from coming to my show while tripping, because I don’t think you need to do trippy things while tripping necessarily. But, I mean, if you’re into tripping a lot, that’s a different thing. What I would hate is for people to come to my show and be like, ’I’ve never tripped before. What more apt time than now to do my first-ever experience than to eat some mushrooms and go and listen to this guy talk about psychedelics?’ Not realizing that a psychedelic state is best when you can go off on your own in your own world for two and a half hours because that’s what you happen to be feeling in the moment. And then you can get back into whatever social conversation when your capacity and attention span are there. But standup comedy requires so much attention, and there’s just a lot going on, and there’s information, and people do it all the time. And I’m like, ’Cool. Hope you had fun.’ And it seems like they do.”
normalized as they are,” he said. “A decent percentage of my audience on this tour hasn’t done psychedelics. And that’s pretty unusual. Usually, if that happened in the past for a psychedelic tour, it was because someone who was really into psychedelics and a huge fan, or whatever, would drag one of their friends that they’d been trying to tell about psychedelics and get them to come and listen to what I say in the show.”

Mauss sees it as his mission to make sure that while his bits are funny and entertaining, they are informative and, above all, that they’re accurate depictions of the psychedelic experience.
“That’s probably the [top] compliment that I get after a show: the accuracy,”
Mauss said. “People are laughing or learning a thing or two here and there. They’re always impressed by the accuracy, which is a hard thing to pull off.”



The history of acid is a rich and storied legacy that traces all the way back to a fateful bicycle ride in 1943, but it wasn’t until the 1970s that blotter paper, dosed with LSD and decorated with tiny designs, took shape as a prominent form of counter-culture iconography. Printed on perforated paper and easily transportable, blotter sheets took center stage for 30 years as the most recognizable and available way to take LSD. Since then, these cultural canvases have become collectors items, and the artform is still being practiced today.





ERIK DAVIS, author of “Blotter: The Untold Story of an Acid Medium,” compiled a history of the art form in collaboration with Mark McCloud, whose legendary collection of blotter art spans over 40 years and tens of thousands of examples. In a lecture at SPUI25, Amsterdam’s academic-cultural center, Davis recounted how amazing the existence of the art form is considering, as he points out, “You don’t need the images to sell the LSD.”
He went on to state that while blotter decoration is unnecessary from the point of view of profit, the images function in a number of different ways including as inside jokes, political commentaries, and as a badge of identity during a time when the cultural push for peace, love and psychedelics was beginning to pull back.
Today, the mainstream interest in psychedelics has never been greater, and you can find a number of artists printing designs on blotter paper for collectors and heads alike. Over at Detroit’s highly respected print house 1XRUN (one-time run), they host an annual show which honors Bicycle Day (LSD’s birthday) by selecting popular names like Tara McPherson, Ziero Muko and Good Trip Studios to imagine what they would create on a sheet of acid.

Zane Kesey is the son of Ken Kesey who, together with Neal Cassady and the Merry Pranksters, helped pioneer the psychedelic experience across the country. He currently runs Key-Z Productions in Oregon where he prints and perforates blotter sheets using a custom-made machine he runs by hand. As 1XRUN put it, “Through Zane’s legacy, the Bicycle Day Collection is deeply connected to a history of creating art on blotter paper.”
Zane is among only a handful of people in the world still creating and releasing blotter sheets. He praised 1XRUN, saying, “They’ve opened up the world of blotter art to this whole new community. Plus, for artists, it’s given them another avenue to make art that they may not have known about before.” He says hundreds of artists contact him about printing their designs on blotter art every year.
“People buy and display them as art, but it also gives someone a chance to reconnect with their history.”
-Printer Zane Kesey
More than just a group show centered on a medium, 1XRUN has taken extra steps to ensure they pay homage to the roots of the movement by teaming up with someone whose involvement in LSD counterculture is part of a family tradition.


He told Leaf how amazing it is to see these become collectibles and how that’s really contributed to the longevity of the medium, saying, “People buy and display them as art, but it also gives someone a chance to reconnect with their history.” For many collectors, that simple picture of an elephant reminds them of a night they saw stars dance and connects them to others who shared a similar experience. Whether you bought a blotter sheet because you love the artist, collect the medium, or wanted a souvenir from your past, the whole medium is a living part of art history and a testament to how a picture can be worth a thousand words.

acidblotter.com
@1xrun
@zanekesey
@zieromuko
@goodtrip
@abrooksart
@mr.melty
@ellie.paisley
@art_by_spectra


For those who dabble in psychedelics and consciousnessaltering substances, there has been a slate of new boundary-pushing technological advances that are blurring the lines between experience and entertainment.
From the massive immersive screens of the Sphere in Las Vegas to Meow Wolf in Santa Fe, ARTECHOUSE in New York City, and the art installations of artists like Refik Anadol and Jen Stark, these venues provide fertile ground for mind-expanding journeys, offering more opportunities than ever for psychedelic enthusiasts to have their minds blown as unique spots pop up across the nation.
This intrepid explorer wrangled up a few heady friends this summer and ventured out to Las Vegas to see Dead & Company’s residency at the innovative new Sphere. This music hub boasts a state-of-the-art audio and visual system designed for immersive experiences.


BY

“I leaned back and made sure I was still holding onto the ground (and reality) as I feared the band might prank the audience by dropping us ‘Tower of Terror’ style”

In addition to Dead & Company-themed graphics, the venue utilized select artists’ work on the world’s largest, most technologically advanced canvas with eye-catching and, at times, psychedelic results.
The building’s interior design was equally impressive in its aesthetics and its functionality.
It was clear that no expense was spared to create a one-of-a-kind consumer experience that perfectly balances simplicity and elegance.
After breezing to our seats, it was only moments before Bob Weir, John Mayer and the rest of the band kicked things off while the massive screens seemed to open up and launch us into what would be an epic ride through the Grateful Dead universe.
As we blasted off from Haight-Ashbury in San Francisco and into the cosmos, it became a jaw-dropping and seat-clinging moment. I leaned back and made sure I was still holding onto the ground (and reality) as I feared the band might prank the audience by dropping us “Tower of Terror” style back down to Earth.
There seemed to be no better place to turn on your (my) lovelight with over 1.2 million exterior and 64,000 interior LEDs that are so bright you can see them from outer space.
As a Deadhead, this pilgrimage felt almost sacred, traversing into the mysterious desert to find a magical oasis so rare it could be mistaken for a mirage. As you approach this glowing beacon in the night, even among the bright lights of the Las Vegas strip, the Sphere’s massive LED exterior stands alone.

However, my anxiety immediately reduced as the band jammed and we started floating through outer space.
The stars began to dance and transform into a vortex tunnel of familiar Dead colors and symbols, as the overwhelming visual experience was clearly in the driver’s seat for this trip.
Innovations like Sphere Immersive Sound, a proprietary concert-grade system powered by German audio titan HOLOPLOT, the haptic response seats strategically used by the band at key moments, and custom venue-specific visuals all added to the show’s impact.
Impressive graphics paired with familiar yet new psychedelic jams included 3D skeletons driving a motorcycle, a giant pirate ship, rainbows and color spirals of all shapes and sizes, famous Dead concert venues and classic iconography. Legendary drummer Mickey Hart’s “Drums and Space” was a particular highlight, taking advantage of the vibrating seats, which added a whole new dimension to the drum solo portion of the show. I was left with my face stolen and my jaw wide open as the band tore through some of their biggest hits with surprising intensity. While this early run clearly limited the band’s ability to completely improvise, it’s a great show that starts to unlock the full promise of where the Sphere can take things in the future.




themicroscopicbitsoffungithatactasthe mushroom’sseed,aredelicateenoughtogetcaught upinaraindroporblownawaybythefaintestbreeze. They’realsorobustenoughtoexistintheharshclimate ofouterspace.Nottomention,eachonecarriesthe genetic information to expand into a vast network of mycelium — the largest of which is still considered the biggest living organism on earth.Mushrooms mightjustbeheretosaveus,andit’sthehumble,tiny sporethat’sgoingtodoit.ForKyleKaszynski,founder ofTheSporeDrop,thesemicroscopicwondersunlock newrealmsofunderstandingandexperiencebeforethey becomethefruitswe’refamiliarwith.
Spores of “magic mushrooms” are legal in the United States for microscopy purposes only, so The Spore Drop collects and presents them to a hungry public of budding mycologists for just that. Observation purposes only.
WHERE MOST STRAIN BANKS have traditionally mailed off a glass slide or cotton swab smeared with a bit of active material, TSD provides a unique solution that marries the clean-roomtype environment needed to ensure a viable sample with the artsy, natural design provided by the mushroom cap. Overnight, the spores collect onto the plate to create a print, each as unique as the whorl on a fingertip. The finished product is a sealed Petri dish with the perfect stamp of the individual first-flush cap that was placed in the dish, with enough spores to provide any mycologist with a literal lifetime of functional fungi.
Kyle and his partners recognize that we’re still in an emerging industry. Now, they’re offering a collection of strains that are attractive to the folks most interested in studying fast-growing, substrate-ag-


nostic, psilocybin-rich cultivars. Their collection of cultivars has been growing over the last decade, including many exotic and wood-loving species that will be ready for closer observation as the industry expands. Kyle adds, “I think that those laws are likely to change, especially in states like Oregon, California and Colorado, where they are fighting for new legalizations.”
Kaszynski’s academic background in mycology gives him an advantage over a space filled with hobbyists. “My master’s thesis was in cultivating oyster mushrooms on various substrates
and determining yields and growth,” he said. The project allowed him to work closely with fungi and experts, simultaneously learning theory and background while studying how mushrooms grow and produce in the wild. “That set me up nicely for my career, consulting and helping teach people about fungi and the specialization in mushroom-producing fungi and the cultivation of those organisms.”
“I think that more and more of these compounds will be discovered, and I think that those can potentially offer medical benefits that are different than the benefits of psilocin and psilocybin.”
-The Spore Drop Founder Kyle Kaszynski
Beyond our own minds, there’s plenty more to explore here. Testing the active ingredients in mushrooms is just starting to become more available, and
we still have so much to learn. Looking toward the future, TSD continues to build its massive strain bank. “I think that more and more of these compounds will be discovered, and I think that those can potentially offer medical benefits that are different than the benefits of psilocin and psilocybin,” Kyle said.
In the same way that the tiniest spore contains the grandest potential, we’re looking at the blossoming psychedelics industry with an eye on how it can benefit our mental health, self-actualizations and society in general. Let’s hope the leaders in the space can maintain the same strict standards and values that The Spore Drop has here, producing something visually striking and scientifically valuable by letting the mushroom lead the way.
thesporedrop.com | @thesporedrop











While Cannabis enthusiasts are familiar with “functional” glass, there is a lesser-known but impressively deep and varied subculture of glass marble makers. These works of art are not only inspired by psychedelics but are also incredibly fun to look at while in altered states.
THESE MINIATURE MARVELS represent a fascinating intersection between glass and psychedelic art. They blend intricately detailed craftsmanship with mind-bending visual effects.
The appeal of psychedelic glass marbles extends beyond their aesthetic beauty. For many, these pieces serve as tools for meditation and focus, particularly during psychedelic experiences. The captivating designs and vibrant colors can provide a sense of curiosity and wonder, helping to guide the mind while enhancing the overall journey.
Within the world of glass marbles, you will find impressively deep creativity confined to small spaces. Artists like Paul Katherman, Tim Keyzers, Jes Durfee and John Bridges have emerged as key figures in the scene, each of whom brings their unique style to the craft.
We spoke with these renowned artists about the role that psychedelics play in their creative process, as well as how collectors experience their art.
Paul Katherman first explored psychedelic realms on the Grateful Dead lot as a teenager while exploring ways to express his creativity. After finding his calling as a glass artist, it’s clear these experiences still impact his approach and his art.
Katherman is renowned for his ability to capture chaos and order within the confines of a marble.
“Color, depth and hidden little spots that you have to explore to find are really important to me. I want my work to be an experience that connects with others through color and patterns that trigger emotions … Marbles are great objects to play with when in an altered state. With 360 degrees of intricate detail and color, it is easy to get lost and take a journey into one of these glass spheres. This is a big reason I love to make them. I want to get lost in every part,” Katherman said.
Alternatively, Tim Keyzers of Washington state has an approach to marble-making that is defined by precision and an almost architectural attention to detail.
His marbles often feature surreal and enchanting elements that take on a fine art vibe. He commonly includes the addition of electroforming metals onto the exterior of his pieces.
“John Bridges' work seems to transcend the artificial concept and design embedded in most marbles created today (my own work included), so the results of collaborating with him are unique,” Tim said of his most recent project with John, entitled “Forge of the Gods."
“Rather than an ‘unfinished thought’ of unfolding technique or developing concept, the work just ‘is’ — a spark of collective consciousness frozen in time. I’m honored to be a part of it.”
John Bridges (Blackfire Glassworks), the spherical synthesist from Oregon, creates mesmerizingly intricate patterns while incorporating playful, fantastical elements in his marbles. His creations evoke a sense of childlike awe, drawing viewers in close to explore incredibly fine detailing work trapped within a tiny glass universe. For those navigating the expansive realms of psychedelia, John’s marbles offer unrivaled depth and detail, making them a delightful addition to any collection.
“With 360 degrees of intricate detail and color, it is easy to get lost and take a journey into one of these glass spheres. This is a big reason I love to make them. I want to get lost in every part...”
-Glass Artist Paul Katherman
Finally, we have Jes Durfee hailing from Wisconsin. He brings an unmatched spirit to each of his pieces focusing on multi-layered scenes. You’re not quite sure if you’ll be wandering through space or navigating a level of “Super Mario Bros.” with how Jes goes beyond the traditional round shape of marbles, applying lapidary skills to his newest pieces.
His work is particularly appreciated by those seeking visual stimulation during their psychedelic journeys. This offers a focal point that grounds you while swirling designs and multiple layers of rich color provide a sensory feast for the eyes. The marbles often feature vibrant colors that seem to dance and shift as they catch the light.
The cultural impact of psychedelic marbles is significant. These tiny, trippy masterpieces have fostered a community of artists and collectors who share a deep appreciation for the craft. Events and gatherings centered around marble glass art allow the opportunity for heady collectors to share their treasures and celebrate the artistry that goes into each piece. The work of these artists not only pushes the boundaries of the medium but also enriches the experiences of those who encounter their art. As appreciation for these intricate orbs continues to grow, so does the recognition of the profound impact that a small piece of glass can have on the human psyche!





With his trademark sunglasses, cigarette holder, and bald head, and his passion for guns, drugs, whiskey, and weed, author Hunter S. Thompson was essentially a living caricature — an iconoclastic figure whose eccentric writing and excessive lifestyle redefined journalism and established him as a hedonistic hero of the counterculture.
Born on July 18, 1937, in Louisville, Kentucky, Hunter Stockton Thompson displayed passions for writing and rebellion at an early age. After a minor crime spree in his youth, he was sentenced to 60 days in county jail for armed robbery at the age of 17. He was paroled after just 30 days, however, on the condition that he enter the Air Force upon his release; he did, and worked at their newspaper, but was discharged a year early due to “his rebel and superior attitude.”

through their misadventures. His book, “Hell’s Angels: The Strange and Terrible Saga of the Outlaw Motorcycle Gangs,” was released in 1967 and was an immediate success.


One of the many escapades detailed in the book is the time that Thompson introduced the Angels to the Merry Pranksters. After meeting Thompson at SF’s public television studio in August 1965, Pranksters co-founder Ken Kesey invited him and the gang to his La Honda home for a huge two-day party the following weekend. It was there that he met LSD guru Richard Alpert and beat icons Neal Cassady and Allen Ginsberg, and where he and the Angels took acid for the first time.
In early 1965, Thompson wrote an article about the Hells Angels biker gang for The Nation, which led to several book offers. As a result, he spent the next year living and riding alongside the Angels

for word. The article “The Kentucky Derby Is Decadent and Depraved” was a frantic, fictionalized, first-person skewering of Southern culture, perfectly complimented by Steadman’s manic expressionist scribblings. Thompson thought he’d totally blown the assignment; instead, many hailed the piece as “a tremendous breakthrough in journalism, a stroke of genius.” One letter of praise from a Boston Globe editor named Bill Cardoso declared: “This is it — this is pure Gonzo.” Thompson loved the term so much that he adopted it as the name of the new type of journalism he’d invented.
After leaving the service, he spent several years as a freelance writer, traveling around the Americas and covering an array of topics for various publications. Then, in 1964, he and his new wife Sandra settled near Haight-Ashbury in San Francisco, where he was first exposed to the emerging hippie counterculture.
In May 1970, Thompson pitched a story about the Kentucky Derby to a short-lived publication called Scanlan’s Monthly. Since he refused to work with a photographer, the editor hired a British illustrator named Ralph Steadman, who flew over from London and met Hunter at the racetrack. The pair apparently hit it off despite Thompson’s excessive drinking and constant threats to mace people. Around a week later, with the rest of the magazine already on press and no coherent story assembled, Hunter tore out pages from his notebook and “telecopied” them to the editor — which, surprisingly, they ended up printing word

In 1968, Thompson and his family moved to Colorado, where he purchased the 110-acre plot of land in the small town of Woody Creek outside Aspen where he would live for the rest of his life — a “fortified compound” he named Owl Farm. Of course, Thompson was just one of countless intellectuals and hippies who had relocated there during the 1950s and ’60s. Many conservatives there, however, didn’t care for the scruffy new immigrants and began persecuting them. One such resident was business owner turned magistrate Guido Meyer, who hung a “No Hippies Allowed” sign at his hotel and vowed to rid the area of the dirty, dope-smoking longhairs — jailing several of them for vagrancy and other minor offenses.




Now, Thompson never identified as a hippie … but after being brutalized by Chicago PD during the protests outside the 1968 Democratic National Convention, he’d become an avowed avenger for civil rights. And so, he decided to get involved.
In 1969, he persuaded Joe Edwards — a biker/lawyer who defended the arrested hippies — into running for mayor and helped manage his campaign. Then, after Edwards lost (by only six votes), Thompson declared his candidacy for Pitkin County sheriff the following year. He ran on what he called the Freak Power Party ticket — a new organization of his own invention, whose official logo was a two-thumbed fist grasping a peyote button. He detailed the Freak Power platform in his debut article for Rolling Stone magazine entitled “The Battle of Aspen” — a catalog of controversial campaign promises that included disarming the police, locking “dishonest dope dealers” up in stocks in front of the courthouse, and decriminalizing personal use and possession of marijuana and other drugs. He didn’t win the election, but his campaign catapulted him into a national media spotlight.
“I have always loved marijuana. It has been a source of joy and comfort to me for many years. I still think of it as a basic staple of life ... and millions of Americans agree with me.”
“Attendance would sometimes increase as much as 50 percent when word spread that Hunter would be there,” says Stroup. “People brought their best weed from around the country just for the chance to share it with Hunter S. Thompson.”
In fact, Stroup recalls one time at the 1977 conference when attendees began throwing joints at Thompson during a panel after he sarcastically chided them for celebrating a minor political win.
“I don’t know what all you people are so happy about,” Thompson reportedly barked. “How can you be in such a good mood when I can’t find any marijuana? All the progress that you’re talking about doesn’t mean shit if marijuana smokers can’t get good marijuana!”


Rolling Stone published many collaborations between Thomp son and Steadman in the years that followed, the most famous of which was “Fear and Loathing in Las Vegas: A Savage Journey to the Heart of the American Dream.” Originally featured as a two-part story in the November 1971 issue (then expanded into a book the following summer), this gonzo masterpiece chronicled the deranged, drug-drenched exploits of Raoul Duke (Thompson) and his attorney Dr. Gonzo (his lawyer friend Oscar Zeta Acosta) during two consecutive trips to Sin City in the spring of 1971. On the second visit, Thompson even attended a narcotics law enforcement conference whose keynote speaker was drug “expert” Professor E.R. Bloomquist, MD — author of a book titled “Marijuana” that claimed to “tell it like it is.” “The reefer butt is called a ‘roach’ because it resembles a cockroach …” Thompson says Bloomquist purported. “‘What the fuck are these people talking about?’ my attorney whispered. ‘You’d have to be crazy on acid to think a joint looked like a goddamn cockroach!’”
& HIGH TIMES
It was in 1972, while covering the Democratic National Convention in Miami Beach, that Thompson first met fellow Cannabis advocate Keith Stroup — founder of the recently formed National Organization for the Reform of Marijuana Laws (NORML). In his 2013 book “It’s NORML to Smoke Pot,” Stroup tells the tale of how he followed the smell of marijuana below the convention center bleachers, where he found Thompson toking up. After introducing himself, Hunter shared the joint with him, thus beginning a 33-year friendship. At Stroup’s invitation, Thompson joined NORML’s board of directors and attended many of their conferences in Washington, D.C., helping to boost the group’s counterculture cachet.
Through Stroup, Thompson also developed a relationship with High Times magazine — doing several interviews and appearing on their cover twice. For the “Celebrities on Pot” piece in their 20th-anniversary issue, Thompson told HT:
“I have always loved marijuana. It has been a source of joy and comfort to me for many years. And I still think of it as a basic staple of life, along with beer and ice and grapefruits — and millions of Americans agree with me. I am not an addict, but I refuse to be without it … marijuana’s gotta be there. I can’t talk about giving up weed.”
SUCCESS, SUICIDE & SENDOFF
In the decades that followed, Thompson’s counterculture cred continued to grow as he embarked on a series of college lecture tours, wrote nearly 100 articles, and published around a dozen books — some of which were adapted into feature films: “Where the Buffalo Roam,” “The Rum Diary,” and “Fear and Loathing in Las Vegas.” Acclaimed Doonesbury cartoonist Garry Trudeau based his character “Uncle Duke” on him, and several filmmakers have released documentaries about him. By the turn of the millennium, Hunter had cemented his status as a literary icon. But despite his outward success, Thompson was suffering internally — both from “unbearable” pain from injuries that had confined him to a wheelchair and from depression. Finally, one Sunday afternoon, he decided he’d had enough. At 5:42 p.m. on February 20, 2005, while on the phone with his wife, Hunter S. Thompson held a .45-caliber handgun to his head and pulled the trigger. Though distressing, his suicide was far from unexpected or out of character: his second wife Anita said that he’d talked about killing himself in the months leading up to the incident, saying that he “wanted to leave on top of his game.” And that was hardly the first time.

“He told me 25 years ago that he would feel real trapped if he didn’t know that he could commit suicide at any moment,” Steadman wrote in his 2006 memoir “The Joke’s Over: Bruised Memories — Gonzo, Hunter S. Thompson, and Me.” “I don’t know if that is brave or stupid or what, but it was inevitable.”
In fact, he and Steadman had already planned his funeral almost 30 years earlier — designing a cannon in the shape of his gonzo fist logo from which he wanted his mortal remains to be fired. And thanks in part to his pal Johnny Depp (who portrayed him on screen), those wishes were ultimately fulfilled: on Saturday, August 20, 2005, at a private ceremony on Owl Farm dubbed “Hunterpalooza,” Thompson’s ashes were launched into the night sky from atop a 153-foot-tall Freak Power tower.
Since his passing, Hunter’s widow has founded the nonprofit Gonzo Foundation, dedicated to promoting literature, journalism and political activism. She also announced a Gonzo Cannabis brand featuring strains cloned from samples of Hunter’s head stash and established two scholarships in his name. NORML, too, has set up a scholarship in Thompson’s name, awarded him a Special Appreciation Award posthumously, and named their annual Media Award after him.



But beyond all the accolades and articles, perhaps Hunter’s greatest legacy is the countless writers and journalists — myself included — that he inspired to trust their inner voices, color outside the lines and let their freak power flags fly. After all, as he famously once said, “When the going gets weird, the weird turn pro.”

For more Cannabis history content, and to listen to our Cannthropology podcast, please visit worldofcannabis.museum/cannthropology.










THERE ARE too many damn choices these days. You wake up, throw on the standard comfort wear and now you’re armed and ready to start ruling out inferior options in almost every aspect of life. Thankfully, some of your choices are predetermined, like which coffee you’ll drink, where you’ll sit at the breakfast table and how to get to where you’re going. Then some are not pre-determined.
And so it begins: whether to shave or go with the rugged look; which entertainment or educational outlet to choose for the commute; whether to speed through the yellow light or ease in and stay put at the crosswalk; how far to stay back from the crosswalk; whether or not to run over the pedestrians crossing the crosswalk and disappear to Mexico. What to have for lunch.

Most presidents go so far as to reduce their everyday clothing to one or two outfits to lower the number of decisions they make daily. Steve Jobs did it. In fact, it has become known that the average human makes around 35,000 decisions in a single 24-hour period, while seven of those are spent sleeping.
Yes, we make decisions while we sleep. Like how to deal with your cat who tells you she wants to move out because she doesn’t like the goofy booties you’re buying for her paws. Or where to hide from the hamburger that is trying to eat you.
Even if you choose not to decide, you still have made a choice.
And choosing doesn’t get any easier when it comes to Cannabis. Will it be a joint, a bowl or a bong hit? A cartridge, an edible or a dab? Sativa, indica or a hybrid? Or choose all of them.
It’s the right kind of burnout.






AVAILABLE AT CURALEAF DISPENSARIES IN NEW JERSEY, NEW YORK, PENNSYLVANIA, MARYLAND, MASSACHUSETTS, AND MAINE.









